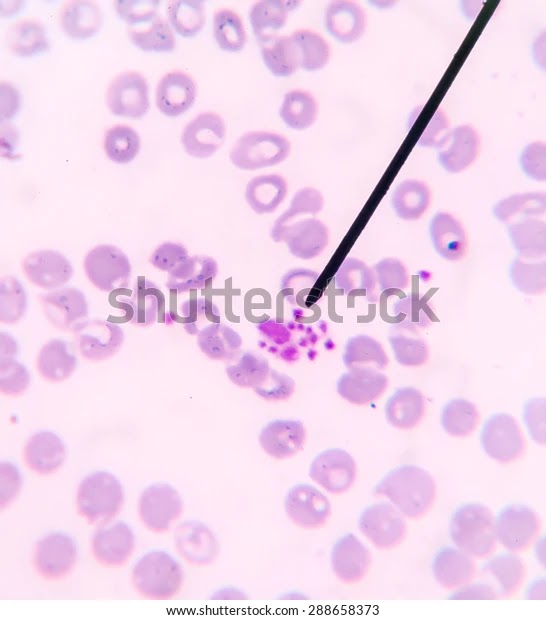

Parisites/vet science
0.0(0)
0.0(0)
Card Sorting
1/37
There's no tags or description
Looks like no tags are added yet.
Study Analytics
Name | Mastery | Learn | Test | Matching | Spaced |
|---|
No study sessions yet.
38 Terms
1
New cards

Avian red blood cell erythrocyte
2
New cards

Calcium oxalate crystals
3
New cards

Cat warble
4
New cards

Cocci bacteria
5
New cards

Coccidia
6
New cards

Demodectic mite
7
New cards

Ear mite
8
New cards

Eosinophill
9
New cards

Flea tapeworm egg
10
New cards

Flea tapeworm
11
New cards

Giardia
12
New cards

Adult heartworm
13
New cards

Heartworm microflaria
14
New cards

Hookworm egg
15
New cards

Hookworm
16
New cards

horse strongyles
17
New cards

Liver fluke
18
New cards

Mammalian red blood cells erythrocytes.
19
New cards

Mast cell
20
New cards

mosquito larvae
21
New cards
22
New cards

Neutrophil
23
New cards
Platlets
24
New cards

Rods bacteria
25
New cards

Roundworm adult
26
New cards

Roundworm egg
27
New cards

Sarcopic mite
28
New cards

Struvite crystels
29
New cards

Taenia tapeworm egg
30
New cards

Taenia tapeworm segment
31
New cards

Tick American dog
32
New cards

Tick black legged deer
33
New cards

Tick brown dog
34
New cards

Tick lonestar
35
New cards

Urate crystals
36
New cards

Whipworm egg
37
New cards

whipworm
38
New cards

Yeast cytology